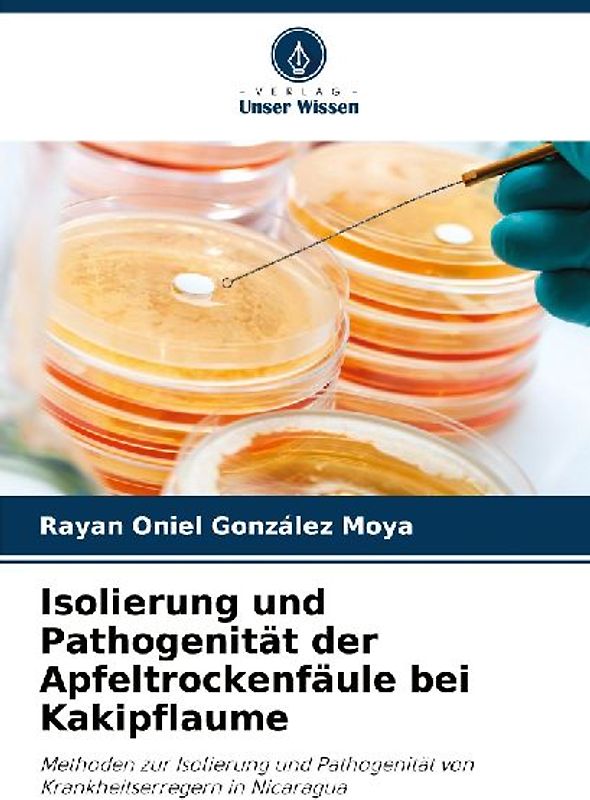
Isolierung und Pathogenität der Apfeltrockenfäule bei Kakipflaume

iPhoneAlle anzeigen
iPhone 11iPhone 11 ProiPhone 11 Pro MaxiPhone 12iPhone 12 ProiPhone 12 Pro MaxiPhone 12 miniiPhone 13iPhone 13 ProiPhone 13 Pro MaxiPhone 13 miniiPhone 14iPhone 14 PlusiPhone 14 ProiPhone 14 Pro MaxiPhone 15iPhone 15 PlusiPhone 15 ProiPhone 15 Pro MaxiPhone 16iPhone 16 PlusiPhone 16 ProiPhone 16 Pro MaxiPhone 16eiPhone 8iPhone 8 PlusiPhone SE 2020iPhone SE 2022iPhone XiPhone XRiPhone XSiPhone XS Max
Galaxy A-SerieAlle anzeigen
Galaxy A12Galaxy A13Galaxy A13 5GGalaxy A14Galaxy A15Galaxy A16Galaxy A17 5GGalaxy A20eGalaxy A21Galaxy A22Galaxy A23Galaxy A24Galaxy A25Galaxy A26 5GGalaxy A32Galaxy A33Galaxy A34Galaxy A35Galaxy A36 5GGalaxy A40Galaxy A41Galaxy A42Galaxy A50Galaxy A51Galaxy A52Galaxy A53Galaxy A54Galaxy A55Galaxy A56 5GGalaxy A70Galaxy A71Galaxy A72
Redmi SeriesAlle anzeigen
Redmi 10Redmi 13CRedmi 15 5GRedmi Note 10Redmi Note 10 ProRedmi Note 11Redmi Note 11 ProRedmi Note 11 Pro Plus 5GRedmi Note 11sRedmi Note 12Redmi Note 12 5GRedmi Note 12 ProRedmi Note 12 Pro 5GRedmi Note 12 Pro PlusRedmi Note 13Redmi Note 13 5GRedmi Note 13 ProRedmi Note 13 Pro PlusRedmi Note 14Redmi Note 14 Pro PlusRedmi Note 8Redmi Note 8 ProRedmi Note 9Redmi Note 9 Pro
- Startseite
Bücher Wissen & Bildung Naturwissenschaft, Medizin, Informatik, Technik Biologie Landwirtschaft & Ernährung Isolierung und Pathogenität der Apfeltrockenfäule bei Kakipflaume
Handgeprüfte Gebrauchtware
Bis zu 50 % günstiger als neu
Der Umwelt zuliebe
Isolierung und Pathogenität der Apfeltrockenfäule bei Kakipflaume
González Moya, Rayan Oniel (Broschiert, Deutsch)
★★★★★
☆☆☆☆☆ Keine Bewertungen vorhanden
Optischer Zustand
Beschreibung
Der Quequisque ist eine krautige Pflanze, die einjährig angebaut wird. Ihr Essen enthält eine hohe Konzentration an Kohlenhydraten und ist von großer wirtschaftlicher Bedeutung für die nicaraguanischen Erzeuger, die diese Pflanze hauptsächlich auf kleinen Flächen in der autonomen Region der südlichen Karibikküste Nicaraguas (RACCS) anbauen, Allerdings ist diese Kultur stark von der Krankheit Mal… seco betroffen, die hauptsächlich durch die Verbringung von Boden und Pflanzenmaterial verbreitet wird, das mit dem Erreger kontaminiert ist, der bisher als Pythium myriotylum identifiziert wurde. Die in Nicaragua übliche Methode zur Isolierung von P. myriotylum ist sehr mühsam, so dass nach praktikableren Methoden und selektiven Nährböden gesucht wird, um Reinkulturen zu erhalten. 43,90 €
oder
zzgl.
Du kannst wie immer einen Kaufalarm setzen, wenn du auf das gebrauchte Buch warten möchtest.
zzgl.
Handgeprüfte Gebrauchtware
Bis zu 50 % günstiger als neu
Der Umwelt zuliebe
Technische Daten
Erscheinungsdatum
17.08.2025
Sprache
Deutsch
EAN
9786208763787
Herausgeber
Bod
Autor
González Moya, Rayan Oniel
Einbandart
Broschiert
Höhe
220 mm
Breite
150 mm
-.-
★★★★★
☆☆☆☆☆ Leider noch keine Bewertungen
Leider noch keine Bewertungen
Sicher bei rebuy kaufen
Schreib die erste Bewertung für dieses Produkt!
Wenn du eine Bewertung für dieses Produkt schreibst, hilfst du allen Kund:innen, die noch überlegen, ob sie das Produkt kaufen wollen. Vielen Dank, dass du mitmachst!
Sicher bei rebuy kaufen

